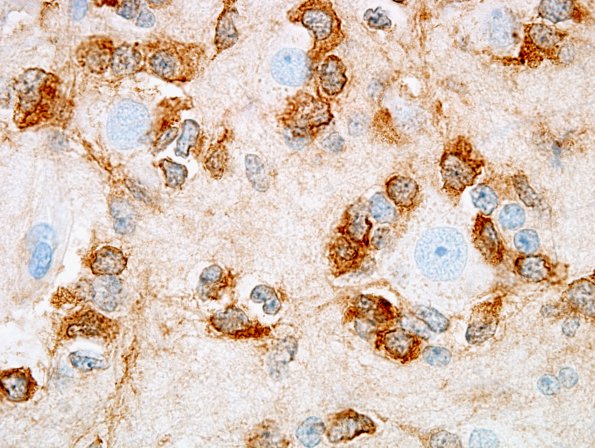
1C2 Oligodendroglioma (Case 1) IDH1 4

Table of Contents
Washington University Experience | NEOPLASMS (GLIAL) | Oligodendroglioma - IDH1 mutant, del 1p19q - Grade 2 | 1C2 Oligodendroglioma (Case 1) IDH1 4
High magnification image of tumor cells surrounding cortical neurons. (IDH1 IHC) ----Not shown: Reactivity for p53 protein is weak, and identified in only rare scattered tumor cell nuclei. Reactivity for proliferation marker Ki-67 (MIB-1 antibody) stains tumor cell nuclei at variable density that ranges up to 6.4%. ---- FISH was performed on paraffin-embedded tissue and deletions of both 1p and 19q were identified.